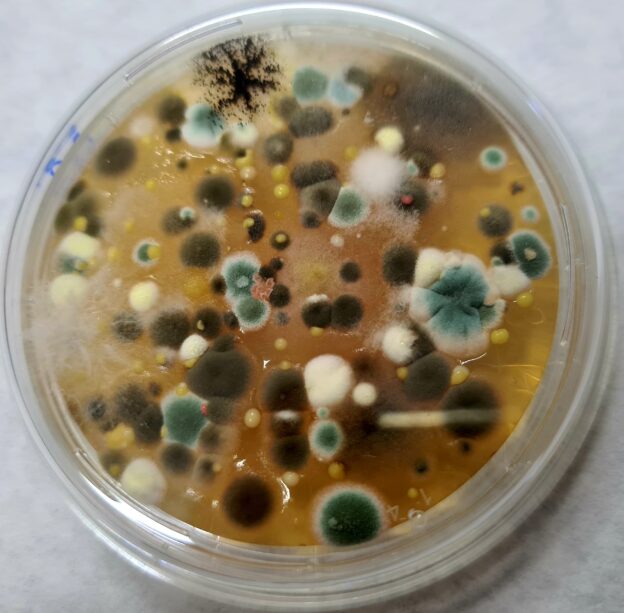
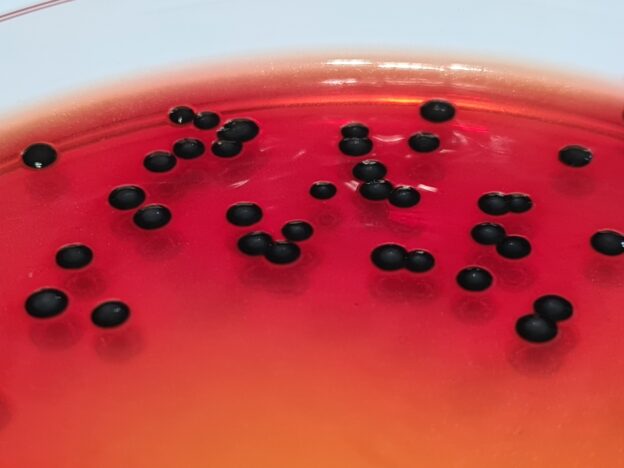
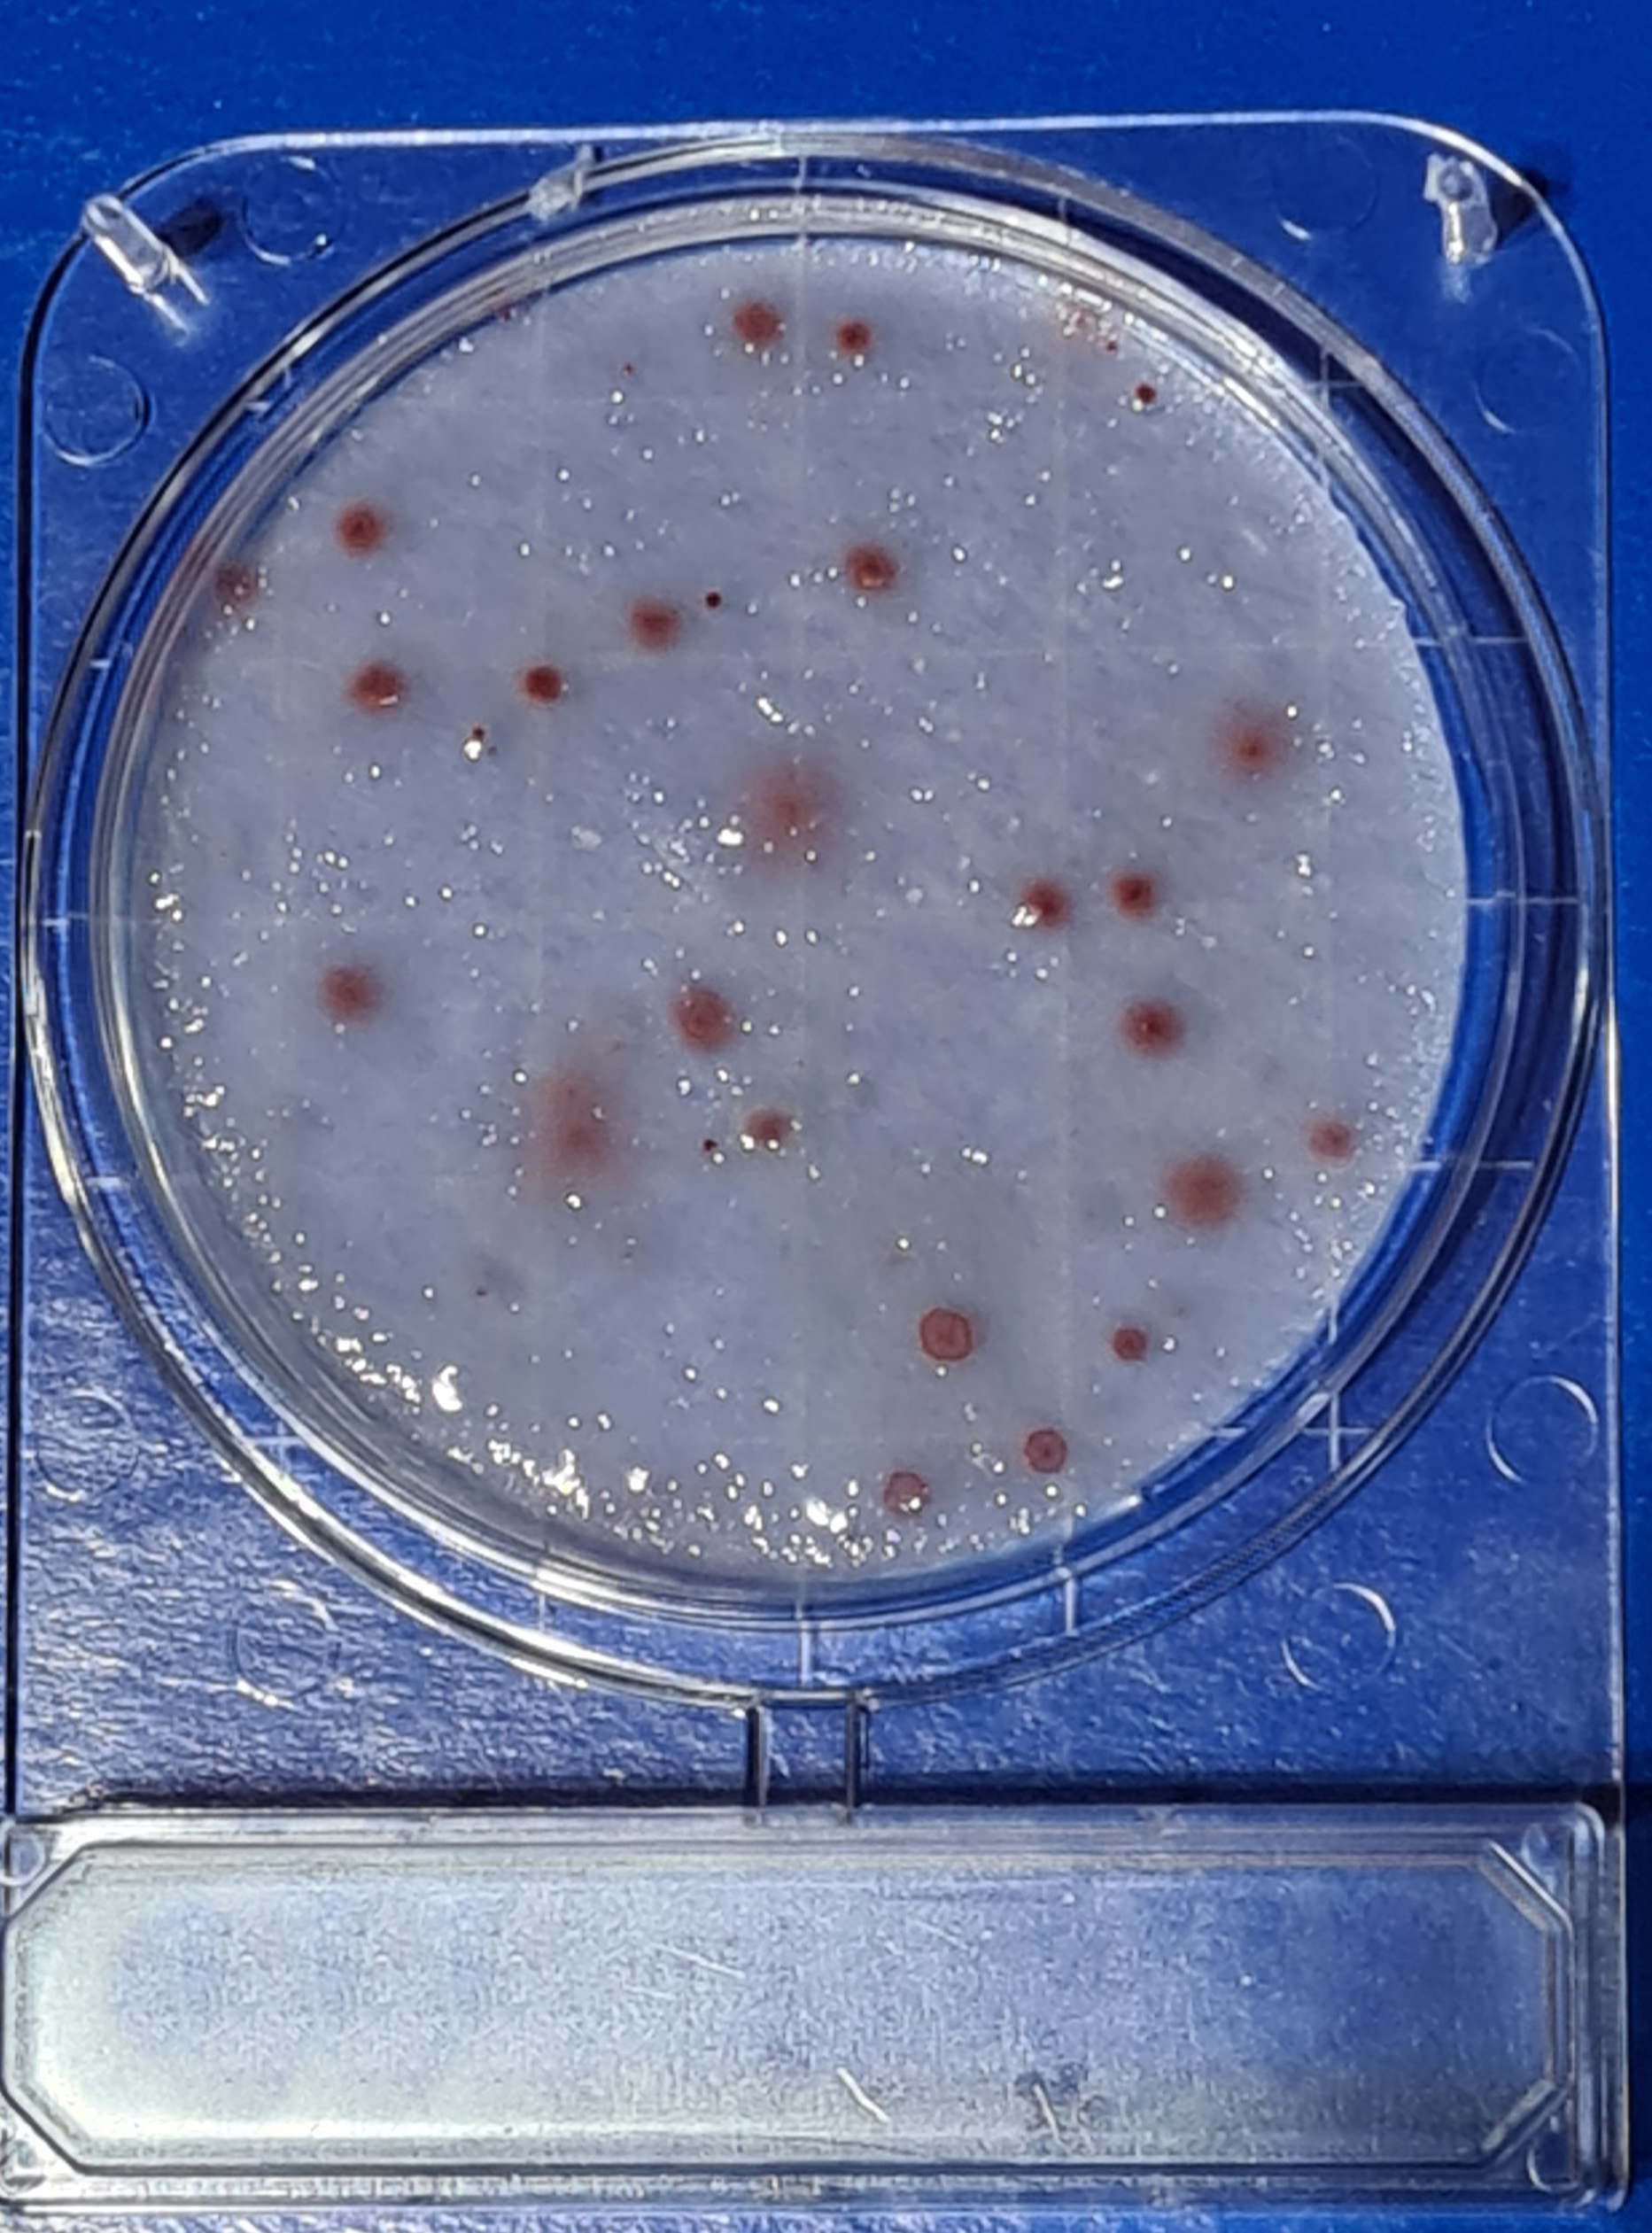
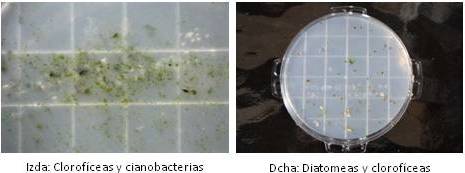

Microbiología del aeroplancton de ambientes interiores
Microbiología del aire
LAS MONOGRAFÍAS DE MICROKIT. Tema 18: Microbiología del aire
Este es un intenso resumen de nuestras 3 publicaciones intercolaborativas sobre microbiología del aire (pioneras en 1999-2002),
del protocolo MICROKIT de control microbiológico del aire con muestreadores de impacto Microflow o MBS (90 páginas),
también del protocolo MICROKIT de control microbiológico del aire en industria agroalimentaria y potabilizadoras (61 páginas),
del protocolo MICROKIT de control microbiológico del aire en industria cosmética y afines (54 páginas),
de los informes de las 13 rondas de Seilambiente (600 páginas),
y del power point de nuestras conferencias internacionales sobre microbiología del aire.
Si desea profundizar en este tema tan poco conocido, puede adquirir por un módico coste los documentos que desee de los mencionados.
También basado en la Norma ISO 100.012 sobre aires interiores, que tuvo en cuenta casi todas las conclusiones que demostramos en dichas publicaciones intercolaborativas pioneras y repasaremos en este monográfico.
1-Microbiología del aire ¿Qué es el aeroplancton?
Son los seres vivos que encontramos en el aire, normalmente bacterias, hongos (levaduras y mohos), polen, esporas, semillas, insectos, ácaros…
Los que realmente nos interesan aquí, al no ser visibles y en un doble sentido:
a) como contaminantes alterativos de nuestros productos fabricados y
b) como vectores de transmisión de enfermedades (en lo que bautizamos en 1999 como “aire no potable”);
son las bacterias y los hongos (levaduras y mohos).
Los virus, como siempre, merecen estudios aparte, al ser algo tan diminuto y que está en el límite entre lo vivo (cuando están dentro de las células que infectan) y lo no-vivo (cuando están fuera), por lo que nada de lo indicado aquí sirve para ellos. No, no especularemos sobre la forma de detección en aire del mayor problema de la actualidad (la pandemia por coronavirus).
A diferencia del plancton acuático, donde la mayoría de organismos es capaz de moverse por sí mismo,
encontramos células que no son capaces de tener movimiento autónomo dentro del aire.
Además, su distribución heterogénea “contagiosa” es extrema, ya que se agregan de forma natural entre sí y a las partículas de polvo,
de modo que en una misma sala hay algunos litros de aire con muchas células y muchos litros de al lado con pocas o ninguna.
De ahí la importancia de un muestreo representativo, de al menos, 1.000 litros (1 m3) por sala (no por placa. luego veremos por qué).
Por otra parte, hay una gran diferencia entre bacterias y hongos (levaduras y mohos) del aire:
las bacterias, procariotas, tienen un tamaño y peso celular que les permite vivir suspendidas en el aire durante meses,
mientras los hongos, eucariotas, ya tienen un tamaño y peso celular que les hace “caer” poco a poco, aunque cualquier mínimo movimiento del aire los puede volver a suspender hacia arriba.
De hecho, en nuestros estudios, hay conclusiones diferentes “contrarias” de otra índole entre bacterias y hongos.
Sólo con estas dos afirmaciones (muestra mínima y no-caída de las bacterias), ya vemos que el método de sedimentación pasiva se queda muy limitado a estudios no comparables entre diferentes usuarios,
sin rigor estadístico, “de andar por casa” y funciona un poco en hongos y muy mal en bacterias.
Además en el aeroplancton microbiano hay dos grandes poblaciones diferentes, independientemente de que sean bacterias u hongos:
la saprófita o “alterativa”, con pico óptimo de crecimiento a 25ºC;
y la asociada al hombre o “patógena”, con óptimo a 35ºC.
De hecho existe una medida de confinamiento de los trabajadores, basándose sólo en la población “patógena”, aunque la saprófita es la más frecuentemente alterativa de los productos que fabricamos, por lo que no podemos olvidarla.
Muchos miembros de ambas categorías se solapan creciendo y detectándose ambas, pero otros muchos no.
Por eso la ISO 100012 olvida algo fundamental: hemos de muestrear por duplicado e incubar unas placas a 25ºC para bacterias y hongos alterativos; y sus duplicados a 37ºC para bacterias y hongos patógenos.
Claramente no es lo mismo el aire exterior de la calle (que por cierto, nos sirve como blanco o, mejor dicho como “negro” de comparación con el de dentro) que el interior.
Ni es lo mismo el interior de una sala blanca que el de una sala de oficinas, de una pastelería o de un matadero.
Por eso hay Normas ISO con valores guía distintos en los diferentes tipos de salas blancas (EN 1632:1994, ISO 14698 -2:2003/COR 1:2004), ISO 14644-3:2005, ver tablas abajo),
quedando los demás aires interiores más desamparados (aunque no tanto como antes del lanzamiento de la Norma ISO 100.012), en una única medida estándar para todos desde 2004:
debe haber menos de 800 ufc/m3 de bacterias + hongos (parece muy tolerante, pero equivale a <1 ufc/L) para considerar “sano” un aire.
Antes de esto, el único estándar (muy similar) fuera de salas blancas lo daba el Ministerio de Trabajo y sólo de forma verbal: 1.000 ufc/m3 (=1 ufc/L) para considerar que un edificio sufre SEE (Síndrome del Edificio Enfermo, en inglés SBS de Sick Building Syndrome)
donde los trabajadores enferman dentro, estando sanos fuera.
Nada de esto tiene en cuenta los alterativos, ya que se refiere a incubaciones a 35ºC, pero podemos extrapolar un valor guía similar para las incubaciones de alterativos a 25ºC.
Similar a la ISO 100.012 de aires interiores, es la derivada UNE 171340:2012 para hospitales (quirófanos, UVIs, salas de espera…)
SALAS BLANCAS
CLASE |
Nº de muestras por lugar |
Volumen por cada muestra (litros) |
Volumen total |
Límite de aceptabilidad cfu/m3 |
| GRADO A |
10 |
1.000 |
10.000 |
< 1 |
| GRADO B |
10 |
1.000 |
10.000 |
max 5 |
| GRADO C |
10 |
1.000 |
10.000 |
max 100 |
| GRADO D |
10 |
1.000 |
10.000 |
max 500 |
PROGRAMACIÓN Y CLASIFICACIÓN DE RESULTADOS DE MUESTRAS EN AMBIENTES CRÍTICOS
|
| Clasificación
de
ambiente |
Nº de
muestras
por lugar |
Volumen de
cada
muestra |
Volumen
total de aire
( litros) |
Nº total C.F.U. en
todas las placas |
Límite de aceptabilidad
C.F.U. /m3 |
| ESTÉRIL |
3 |
1.000 |
3.000 |
0 |
0 |
| CLASE I |
3 |
1.000 |
3.000 |
15 |
5 |
| CLASE II |
2 |
1.000 |
2.000 |
30 |
15 |
| CLASE III |
2 |
1.000 |
2.000 |
150 |
75 |
| CLASE IV |
2 |
1.000 |
2.000 |
200 |
100 |
PROGRAMA Y CLASIFICACIÓN DE RESULTADOS DE MUESTRAS EN AMBIENTES NORMALES
|
| Clase
Ambiente |
Nº de muestras
Por lugar |
Volumen
de cada
muestra (l) |
Volumen total
de aire
(litros) |
Nº total C.F.U. en todas las placas |
Límite de aceptabilidad
C.F.U./m3 |
| Grado 1 |
2 |
180 |
360 |
36 |
100 |
| Grado 2 |
2 |
180 |
360 |
90 |
250 |
| Grado 3 |
2 |
180 |
360 |
180 |
600 |
| Grado 4 |
2 |
120 |
240 |
180 |
750 |
| Grado 5 |
2 |
120 |
240 |
240 |
1000 |
| Grado 6 |
2 |
120 |
240 |
360 |
1500 |
| Grado 7 |
1 |
60 |
60 |
120 |
2000 |
Hemos visto en esta introducción por qué debemos muestrear rutinariamente el aire donde trabajamos.
Máxime si conocemos este otro dato: Los mayores emisores de biocontaminación al aire son, por este orden:
1-Los laboratorios de microbiología, sobre todo las estufas de cultivo y los filtros de las cabinas de flujo laminar poco antes de que tengan que ser cambiados;
2-los aparatos de aire acondicionado;
3-las depuradoras de aguas residuales;
4-los mataderos;
5-las tiendas de mascotas;
6-las personas y sus mascotas;
7-las macetas con plantas y tierra;
8-los alimentos; 9-aire exterior que entra sin filtrar.
Como siempre, los microorganismos se multiplican en base a un triángulo con tres factores básicos: alimentos, humedad y temperatura; no se lo pongamos fácil:
eliminemos la materia orgánica (suciedad y residuos de alimentos),
reduzcamos la humedad ambiental (al menos por debajo del 35%)
y bajemos la temperatura al mínimo que los trabajadores nos permitan (ideal temperatura de nevera, si no, al menos, temperatura primaveral (18-21ºC) durante todo el año.
2-Microbiología del aire: Métodos de muestreo.
Tantas Normas ISO sólo tienen una cosa en común:
Todas eligen el muestreo mediante muestreadores de impacto
(ni sedimentación pasiva, ni centrifugación, ni filtración, ni impingers de burbujeo, ni el invento del tbo del “listo del secador de pelo”);
por eso antes de 2004 sólo podíamos elegir entre 3 ó 4 muestreadores de impacto en el mercado (SAS, Microflow, MBS y poco más), y ahora hay más de 20.
De todas formas el número de laboratorios que todavía usa sedimentación pasiva supera el de los que ya usan muestreador de impacto,
por una cuestión simplemente económica, aunque nos sorprende la cantidad de muestreadores que llevamos vendidos desde 1999 y que aun sigamos vendiendo centenares al año (entre España e Iberoamérica).
En la sedimentación pasiva
(el método que nos enseñaron en la Universidad), dejamos abiertas placas de 90 mm durante ½-4 horas (el tiempo depende de muchos factores)
en lugares bien elegidos (que no las pisen los operarios, que sean puntos críticos, que sean representativos…),
incubamos y damos el recuento en nº de colonias por placa
(se supone que sería la columna de aire de la altura de la sala por los 63,6 cm2 de la placa aunque no es cierto ni de cerca, ya que las bacterias no caen; ni los hongos que caen, llegan desde arriba del todo de esa columna).
Cualquier intento de correlacionar el recuento por sedimentación pasiva con el método de impacto fracasa, por lo que las fórmulas que los asocian, son sesgadas.
Hay mucho que decir sobre los medios de cultivo que se deberían usar, su composición, el aditivo que necesitan para evitar el efecto desecación de la superficie de la placa y el volumen necesario de medio por placa (ver capítulo 3 de esta monografía).
En cuanto al muestreo de impacto,
se trata de impactar, a una velocidad de flujo laminar, un volumen concreto de aire contra un medio de cultivo.
Por eso aquí la comparación entre distintos laboratorios es estándar, no como en la sedimentación pasiva, donde la caída de microorganismos al medio de la placa depende de múltiples factores no controlables.
De entre los más de 20 muestreadores de impacto que hay hoy día en el mercado ¿Cuál elijo?
Hay una Norma ISO dedicada sólo a responder esta pregunta, y que te deja más o menos igual que antes de leerla… pero la solución es más fácil.
¿Cuáles son los muestreadores veteranos, que crearon escuela y de los que surgió la ISO 100.012?
Lo hemos contestado arriba
¿Con cuál de los muestreadores veteranos se concluyó en los estudios intercolaborativos de 1999-2002 que se obtenían mejores resultados y por qué?
Microflow a caudal bajo (0,5 L/seg = 30 L/minuto), el único que cumple la ISO 100.012 en este tema por su máxima exactitud.
¿Cuál es el que más unidades tiene vendidas en el mundo y por qué?
MBS, por ser más económico (al alcance de todos), robusto (no necesita más mantenimiento que las calibraciones periódicas: no se estropea), ligero menos de (1 Kg), con pilas AA (en vez de baterías especiales que hay que importar y de las que dependen todos los demás muestreadores)…
y lo que nadie sabe: comparamos los recuentos obtenidos y ¡¡¡supera la exactitud del Microflow a 0,5 L/seg, tardando 3 veces menos en muestrear el mismo volumen de aire!!!
3-Incertidumbre: ¿Estoy haciendo algo mal en mis muestreos? Puntos críticos en el muestreo de microbiología del aire.
Si seguimos muestreando por sedimentación pasiva (placas abiertas), al menos hagámoslo lo mejor posible.
Vemos laboratorios que abren las placas 5 minutos en vez de media hora o más “porque si no, las placas se les secan”.
Y es que las placas para muestreo de aire (sea por sedimentación, sea por impacto) deben ser especiales para soportar tanto tiempo abiertas o tanto aire que les impacta;
deben tener mucha cantidad de medio
y deben tener un agente antidesecante que retrase su desecación (como el SBL001 de Microkit);
los fabricantes de placa y Rodac no se han molestado en tener en cuenta todo esto, siguen fabricando Rodac para superficies y placas para siembras normales,
y de momento sólo Microkit ofrece placas especialmente preparadas para muestreo de aire, con 20-25 mL en vez de los 15 mL habituales de las demás marcas,
además de tener el agente antidesecante.
No hablemos del uso de laminocultivos (Dipslides) o placas deshidratadas (DryPlates, Petrifilm, CompactDry…) en microbiología del aire, sólo diremos que no sirven para nada.
Pero supongamos que hemos desterrado la sedimentación pasiva y nuestra empresa nos ha comprado ya nuestro anhelado muestreador de impacto.
Hagámoslo bien en muestreo de impacto, y no perdamos el tiempo en hacerlo mal y obtener resultados mediocres.
Tengamos muy en cuenta estos 12 puntos críticos que hemos detectado en estas 2 décadas:
3.1-Microbiología del aire: Velocidad de impacto del aire y las células sobre el medio de cultivo
No permita que los microorganismos “se estrellen” contra el medio de cultivo (blando, pero con tensión superficial sobrada para destruir células impactadas a alta velocidad) y se hagan inviables por deterioro celular.
Pregunte la velocidad de impacto del muestreador que va a adquirir, ya que las Normas ISO aconsejan que sea la mínima posible (y máximo 11,6 m/seg).
En bacterias la diferencia entre una y otra velocidad de impacto es crucial: a velocidad baja se obtienen recuentos el doble (207%) que a velocidad alta;
en hongos no afecta tanto (se recupera un 115% a velocidad baja respecto a la velocidad alta).
3.2-Microbiología del aire: Caudal (litros impactados de aire por minuto)
No confunda velocidad de impacto con caudal de muestreo, están en correlación (a más caudal más velocidad) pero no tienen nada que ver,
la primera mide m/seg y la segunda mide L/seg.
El caudal estándar de prácticamente todos los muestreadores del mercado es de 100 L/min (1,67 L/seg), por lo que dado un volumen de muestreo concreto (ej: 1.000 L), todos acaban de muestrear a la vez: 10 min
(una de las primeras preguntas más reiterativas de quienes están decidiendo cuál muestreador comprar, porque les preocupa perder su tiempo inútilmente).
Sólo Microflow ofrece, además de este caudal llamémosle “de Riesgos Laborales”, otros 4 caudales:
0,5 L/seg (30 L/min) para máxima suavidad en el muestreo (que obtiene en los recuentos hasta un 200% por encima del caudal estándar de los demás muestreadores y capta más positivos en salas presuntamente estériles),
1 L/seg (60 L/min),
1,5 L/seg (90 L/min) y
2 L/seg (120 L/min) para muestreos con prisa (ej: aires muy sucios como los de las depuradoras de aguas residuales o mataderos, de los que deseamos alejarnos cuanto antes).
Tambien un MBS especial (MB2 High Flow) funciona todavía más rápido, a 3 L/seg (180 L/min) para usuarios de este tipo de lugares de alta contaminación y para quienes necesitan hacer muchos muestreos en el mismo día.
En realidad lo importante, más que el caudal, hemos podido constatar tras la emisión de la Norma ISO 100.012, que es la velocidad de impacto,
la cual es directamente proporcional al primero, pero depende de otros factores, como la distancia de los poros del cabezal al medio de cultivo, las turbulencias que se forman dentro del cabezal, el uso de placas convexas en vez de placas planas…;
sólo así se explica que MBS a caudal estándar (1,66 L/min) recupere todavía más colonias que Microflow a 0,5 L/seg.
3.3-Microbiología del aire: Efecto rebote
Algunas células impactan en el medio de cultivo, pero rebotan y por tanto no constan luego como colonias/placa.
El factor limitante en este efecto rebote (aparte de los ya vistos: velocidad de impacto y caudal de muestreo) es la dureza de la superficie del medio de cultivo, que depende de los g/L de agar-agar del medio empleado y del uso de agentes que rompan su elevada tensión superficial;
Las Rodac de Microkit (Envirocount) están fabricadas con el agente antidesecante, que es también un antiburbujas porque reduce la tensión superficial del medio.
Por eso nadie más fabrica ni puede fabricar placas así, porque las Rodac fabricadas automáticamente con antidesecante se desbordan y estropean, al moverse antes de que estén sólidas,
mientras las Envirocount están fabricadas como las haría Ud. mismo, a mano, y no se mueven de la cabina de flujo laminar con la presión positiva encendida hasta que están sólidas.
3.4-Microbiología del aire: Efecto “paso de largo, no impacto en el medio”
Otro efecto colateral al uso de muestreadores de impacto es su diseño, ya que en los menos eficientes, mal diseñados, hay una importante proporción de aire turbulento que pasa de largo por el muestreador sin impactar en el medio de cultivo, por lo que los microorganismos así captados son devueltos al aire y no aparecen luego como colonias en el medio de cultivo.
3.5-Microbiología del aire: Placa convexa “Rodac” versus placa clásica
Otro origen de turbulencias que reducen la efectividad del muestreo de impacto por “efecto paso de largo” es el tipo de placa:
La placa de 90 mm, que tanto gusta elegir a los usuarios noveles en muestreo de impacto, tiene un gravísimo problema que nos hace llevar 2 décadas de campaña contra su uso en muestreo de impacto del aire
(aunque algunos muestreadores como el MBS permitan usar ambos tipos de placa con sólo ajustar una pestaña del cabezal, por presiones que reciben los fabricantes de muestreadores por parte de los usuarios que desconocen este problema):
sí, la placa de 90 mm es cierto que tiene más superficie donde el aire puede impactar, que una placa de 55-60 mm, pero la realidad es que recupera muchísimas menos colonias (1/3) que la placa Rodac aunque ésta sea de menor diámetro.
El motivo es que en la placa Rodac la superficie del medio es convexa y no hay una pared de plástico alrededor del medio, que actúa en las placas de 90 mm como “cordillera” y como tal crea graves reflujos y turbulencias en el aire que va a impactar en el medio.
Es más, si tenemos la curiosidad de emplear placas no convexas de 55-60 mm (las de filtración de membrana en aguas), el reflujo de más proporción de cordillera por cm2 de superficie de medio, es aún más devastador que en las de 90 mm y el recuento queda reducido a su mínima expresión.
Y si usamos placas de 90 mm llenas hasta el borde (lo cual resulta demasiado difícil de fabricar-embolsar como para que nadie las comercialice),
nos encontramos en la situación óptima, con recuentos maximizados por tener más superficie de impacto y por no haber cordilleras de plástico alrededor.
3.6-Microbiología del aire: Volumen de muestra versus “efecto desecación” de la pared celular, no sólo del medio de cultivo
Por todas partes vemos escrito que la muestra mínima de aire por sala ha de ser de 1.000 L, pero pocos hemos estudiado cuál es el punto de inflexión POR PLACA de lo que los biólogos llamamos en Ecología “curva esfuerzo/captura”: cuál es la mínima muestra representativa en microbiología del aire por cada submuestra de los 1000 L ó 1 m3.
Y el número mágico que demostramos hace ya más de 20 años es de 200 L/placa;
si tomamos 300 L, o 500 L, el recuento es prácticamente el mismo, porque las bacterias que impactaron al principio en la placa se han hecho inviables y al final en 1.000 L por placa, sólo sobreviven las de los ultimos 200 litros.
Esto significa que estamos multiplicando nada menos que por 5 el recuento al hacerlo bien, y acercándonos paso a paso, a la realidad de ufcs que hay en el aire.
Es decir, cada muestra de 1.000 L, debemos tomarla en 5 placas Rodac, y en cada una de éstas, muestrear 200 L.
A pesar de lo que pueda parecer, esto no nos complica el muestreo en absoluto, ya que el m3 por sala, no debe tomarse en un único punto:
debe tomarse en 5 puntos diferentes dentro de la misma (ver punto 3.10 de esta monografía), de modo que sólo hemos de cambiar la placa al cambiar a cada nuevo punto.
Y por supuesto, tras incubar, hemos de sumar los resultados de las 5 placas para obtener el recuento más real por m3.
La única consecuencia es que hemos de usar 5 placas, y no 1 placa, por cada sala.
Sumando a esto el punto 3.8 de esta monografía, serán 10 placas/sala.
¡Cuántas cosas se pueden hacer mal (muy mal) al muestrear el aire!
En zonas tropicales la biodiversidad aumenta de forma exagerada; no sólo en aves, o en especies de hormigas por árbol: cuando estuvimos allí todo el año 2015, pudimos constatar la cantidad de especies nuevas para la ciencia de bacterias y hongos que descubrimos allí en el aire, hasta que nos cansamos en gastar dinero en sus identificaciones moleculares:
era un sin parar.
Y también pudimos comprobar su elevadísima concentración, por eso allí es más difícil fabricar cualquier cosa sin que finalmente acabe con problemas microbiológicos.
Las placas de 200 L de aire literalmente “se abren solas” durante su incubación (y en superficies el método de contacto debe ser sustituido por el escobillón para evitar los resultados incontables).
Tuvimos que modificar nuestros protocolos especificando que en zonas tropicales se tomen 50 L/placa, no 200.
Lo que no es tan clara es la necesidad de tomar 20 placas/sala, es decir 1m3 (salvo en salas blancas) en zonas tropicales.
3.7-Microbiología del aire: Medios de cultivo más adecuados
No existe una Norma ISO a la que menos caso se haga que la ISO 100.012 de aires interiores. Tristemente ni siquiera los auditores de acreditación parecen conocerla, con lo exigentes que son en otros temas menos comprometedores con la calidad de un análisis.
Decimos esto porque seguimos encontrándonos con mayoría absoluta de laboratorios que muestrean el aire haciendo caso omiso a todo lo que llevamos revisado en esta monografía.
Incluido lo siguiente: emplean TSA ó PCA para bacterias y Sabouraud para hongos.
Cuando hace ya más de 22 años que demostramos (y lo recalca así la ISO 100.012 tras hacer sus propias comprobaciones con miles de muestras comparadas) que los medios que mejor funcionan en impacto de aire son:
el LPT Neutralizing Agar (con el añadido “lilac” en dicha ISO, que nosotros llamamos “purple”) para bacterias;
y el Rosa Bengala CAF Agar para hongos (después hemos comprobado que también es perfectamente equivalente en aires el posteriormente conocido medio DRBC Agar (Dicloran Rosa Bengala Caf Agar, más famoso en industria alimentaria por la ultima ISO de recuento de hongos en alimentos, la ISO 21527).
3.8-Microbiología del aire: Temperaturas de incubación e índice de confinamiento
Ya hemos comentado que existen 2 poblaciones microbianas diferentes que nos resultan del máximo interés: la asociada al hombre (de 35ºC) y la alterativa (de 25ºC).
Ambas tienen una zona solapada (microorganismos con óptimo de crecimiento a ambas temperaturas) pero también zonas sin intersección, por lo que deben estudiarse ambos recuentos.
Debe estudiarse el índice de confinamiento (recuento a 35ºC dividido por recuento a 25ºC) para saber si es superior a una cifra (hay demasiadas personas emitiendo microbios en una sala), generalmente 1, y levantar acción correctora para reducir su número.
3.9-Microbiología del aire: Número de poros del cabezal y tabla NMP
Los estudios que han creado escuela, antes de la emisión de la Norma ISO 100.012, se han hecho siempre con los muestreadores veteranos, que tenían 220 poros en su cabezal, y para los que se desarrolló la tabla NMP de corrección,
que se refiere a las zonas del cabezal sin poro, que provocarán 1 sola colonia aunque caigan por un poro varias ufcs.
Han surgido después varios muestreadores con 400 ó 1000 poros por cabezal; si no crean su propia tabla NMP, no se puede emplear la tabla clásica; por tanto no ofrecen dicha corrección:
La diferencia es enorme: con 220 poros las recuperaciones son un 147% mayores en bacterias y un 625 % mayores en hongos que con 1000 poros, por turbulencias, efecto rebote, efecto paso de largo… y otras muchas variables que estamos explicando en esta monografía.
3.10-Microbiología del aire: Frecuencia y lugar de los muestreos
Hay que ser coherentes, no podemos muestrear el aire una vez al mes, para eso no muestreemos ninguna.
Eso es como si eligiésemos al azar un lote de producto final al mes y extrapolásemos que los demás lotes del mes están igual.
Lo mismo que hay fábricas que consideran que una muestra es diferente cada 5 minutos de producción, otras que cada lote debe muestrearse con una muestra del principio, otra del medio y otra del final, y otras que consideran que un lote equivale a una muestra,
en el aire elegiremos cual es nuestro caso.
Fuera de salas blancas, quirófanos o UVIs, qué menos que un muestreo (en presencia de operarios) al día, o varios a lo largo del lote si es un solo lote de producción continua al día.
Por otra parte el volumen mínimo ya lo hemos comentado: 1 m3,
aunque hay quien prefiere calcular la raíz cúbica del volumen de la sala (normalmente salen cifras similares a 1 m3).
Pero sea como sea, la muestra mínima de 1 m3 jamás debe impactarse en una sola placa,
sino en la suma de 5 placas (200 L/placa).
¿Donde tomar esas 5 submuestras?
Normalmente una en cada una de las 4 esquinas y otra en el centro,
pero también hay que considerar los puntos críticos: salida del aire acondicionado, puerta de entrada, ventanas abiertas si las hay, incubador del laboratorio, cabina de flujo laminar, zonas con más personal confinado, rincones y zonas donde se puede estancar el aire por ausencia de movimiento…
¿Es suficiente en los laboratorios de microbiología, muestrear la cabina de flujo laminar?
Evidentemente no, a no ser que nos dé igual respirar aire no potable mientras nuestros cultivos no se nos contaminen…
3.11-Correlación nula entre microbiología del aire y la microbiota de las superficies anexas
Una de las primeras curiosidades que descubrimos en nuestros estudios intercolaborativos de 1999-2002, fue que los recuentos del aire no presentaban correlación alguna con los recuentos de las superficies circundantes.
Es decir, que no podemos extrapolar de un aire limpio, unas superficies limpias, ni viceversa.
Una vez conocido este dato, resulta lógico, ya que en general habrá más suciedad orgánica en las superficies que en el aire y, en la otra cara de la moneda, no se suelen aplicar con tanto esmero ni tanta regularidad los desinfectantes del aire como los de superficies.
3.12-Microbiología del aire: Necesidad del test de biodiversidad (comparar la población interna con la externa para ver si estamos multiplicando cepas concretas en el interior)
Los recuentos son una indicación, pero no son lo único que nos interesa de la microbiota del aire.
Es muy importante comprobar si estamos facilitando a alguna cepa su proliferación dentro de nuestras instalaciones.
Y para ello toca identificar y estudiar la diferencia entre el aire interior y el exterior, de ahí la importancia de los “negros” en la calle.
Las cepas del aire a menudo suelen ser microbiota mixta de especies de bacterias
(las más frecuentes son de los géneros Micrococcus, Staphylococcus, Bacillus, Pseudomonas, Arthrobacter, Exiguobacterium, actinomicetes…),
levaduras (Rhodotorula…)
y mohos (Alternaria, Aspergillus, Stachybotrys…),
además de microalgas aerofíticas, si nos interesan.
El problema es que las galerías de identificación se diseñaron para microbiología clínica y aunque algunas se estén continuamente actualizando con las cepas que encuentran los usuarios, siguen dando resultados mediocres (probabilidad < 95%)
e incluso erróneos (dicen que es una cepa cuando en realidad es otra).
La identificación molecular (secuenciación genética y algo menos la espectrometría de masas Maldi tof) acaban con este problema, ya que la base de datos actual es inmensa, sobre todo en el caso de la secuenciación genética.
De este modo se descubren continuamente nuevas especies para la ciencia.
Spearman inventó un coeficiente estadístico de biodiversidad.
No hace falta, para hacer un test de biodiversidad es suficiente con comprobar que no hay más microorganismos en el interior que en el exterior (ufc int/ufc ext <1) y si se trata de colonias repetitivas de las mismas o de diferentes especies que en el exterior.
4-Microbiología del aire ¿Y después del muestreo, qué?
Cuando, gracias al muestreo, sabemos que nuestro aire no es potable (desde el punto de vista de la población a 35ºC supera los 800 ufc/m3,
es decir, obtenemos una media de más de 160 colonias de bacterias + hongos por placa de 200 L cuando hemos tenido en cuenta todo lo explicado en esta monografía)
o cuando concluimos que se trata de un aire alterativo (la población a 25ºC o la población a 35ºC supera dicha cifra o, en salas blancas, la de las tablas antes insertadas)…
¿qué hacemos?
La solución a la No Conformidad es simple: desinfectar y repetir el muestreo hasta que los valores se reduzcan drásticamente.
En general con la primera desinfección no es suficiente y toca repetir 5 días seguidos para alcanzar niveles base que nos den confianza en que no se volverá a repetir (al menos en un largo periodo de tiempo).
Tambien hay que añadir a la desinfección química, una limpieza física para eliminar la materia orgánica que está generando la proliferación microbiana.
Eso es fácil de decir en superficies, pero en aire de salas que no son blancas y por tanto el aire no se filtra, la solución está en que dichas partículas de materia orgánica se adhieran a partículas que caen por su propio peso.
La respuesta a ambos temas son los sprays de niebla Airesano,
primero porque desinfectan (contra bacterias y hongos) con el menor riesgo para las personas (hasta el punto de ser el único spray desinfectante que puede utilizar cualquier persona, al estar declarado por el Ministerio de Sanidad como “de uso doméstico”);
y segundo porque su tamaño de partícula permite que caigan al suelo partículas más pequeñas de materia orgánica y de polvo inorgánico que atrae electrostáticamente a las células microbianas.
Una vez en el suelo, la limpieza y desinfección de superficies se encarga de acabar de erradicar ambos problemas (materia orgánica y microorganismos).
Airesano se aplica en ausencia de personas, pulsando el botón especial que se queda clavado y descarga la niebla; y yéndose de inmediato.
Aunque se puede ver por la ventana de la puerta, que en 1 minuto se ha vaciado y en 10 minutos la niebla sedimenta en el suelo; el efecto residual para humanos obliga a no volver a entrar en 3 horas, por lo que se aplica a ultima hora de la tarde, antes de irnos del trabajo.
No deja residuo alguno, sólo un agradable olor limón-menta.
Para aires tan sucios conviene usar Airesano 5 dias consecutivos.
La dosis posterior “de mantenimiento” es de 1 vez por semana.
No se puede rotar de desinfectante como en el caso de las superficies, al ser el único con licencia de uso doméstico.
Para aires “catastróficos” que no se han analizado nunca y demuestran una falta total de higiene hasta la fecha, es mejor contratar los servicios profesionales de empresas de fumigación microbiana, que emplearán glutaraldehido, formol y otros desinfectantes fuertes
que deben aplicarse en ausencia de personas, y no permiten la entrada hasta 2 días después, por lo que se aplican los viernes por la tarde-noche para que actúen durante el fin de semana,
y aunque a la vuelta haya que limpiar los residuos y abrir las ventanas, se reducirá seriamente la carga para poder aplicar posteriormente de rutina el Airesano.
En este video lo entenderá todo mejor:
https://www.youtube.com/watch?v=rruGElrCBqk&t=12s
5-Cómo vemos el futuro de los muestreos de microbiología del aire
Un año después de dar una de las conferencias en las que se inspira este monográfico, nos habían llegado pedidos récord de 100 muestreadores MBS del mismo país.
La microbiología del aire ha arrancado y su control de forma correcta (ISO 100.012 y, además, todo lo explicado aquí) son imparables.
El criterio profesional seguirá siendo lo más valioso para tomar decisiones, por ejemplo, lo no comentado aquí, como sería por ejemplo la necesidad de buscar hongos dermatofitos a 35ºC en las salas de micología de hospitales,
estudiar el gradiente de microorganismos conforme nos alejamos de la depuradora y nos acercamos a la población…)
Si desea la monografía completa en pdf (con fotografías y gráficas que no salen aqui), solicítela en consultastecnicas@microkit.es
“No hay mejor legado que enseñar a los compañeros de profesión que así lo desean, lo que nos ha costado tanto trabajo aprender”
https://www.microkit.es/microbiologia-de-superficies-ambientes.htm